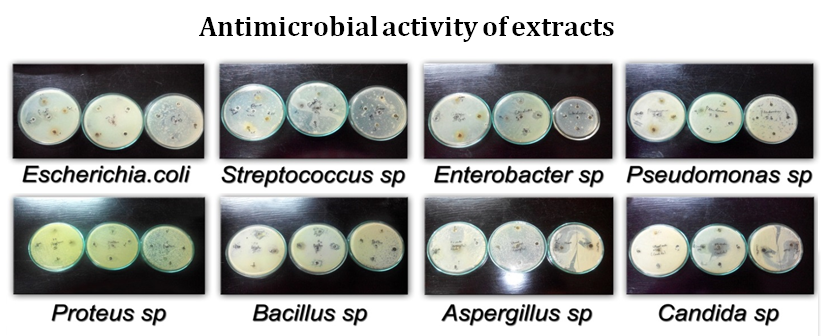

PG and Resarch Department of Biotechnology, Women’s Christian College, Chennai 600006, Tamilnadu, India
Email: dr.anchanababu@gmail.com
Received: 17 Oct 2015, Revised and Accepted: 22 Dec 2015
ABSTRACT
Objective: Saraca asoca which is also called Saraca indica is the ancient tree of the family Caesalpinaceae. This tree is considered as the first in medicinal values since the Buddist period. Ashoka is traditionally used in the treatment of excessive uterine bleeding, dysmenorrhoea and depression in women. It is also used to treat inflammation, indigestion and also abnormal vaginal discharge. It is found to have antimicrobial, anticancer, antimenorrhagic, anti oxytocic activities. The study focuses on to isolate and characterizes the bioactive compounds from the leaves of Saraca asoca by cold extraction method.
Methods: The crude extracts of ethanol, petroleum ether, and aqueous extracts were spotted in TLC plate to fig. out the number of probable compounds in each extract. Column chromatography was performed to collect purified fractions. Phytochemical screening of crude samples were tested, the presence of flavonoids, steroids, tannins, alkaloids, glycosides, phenols, reducing sugars were identified. Antimicrobial activity of ethanol, petroleum ether fractions were tested using agar-well diffusion method, maximum activity was recorded in a concentration-dependent manner against Escherichia coli, Staphylococcus sp, Streptococcus sp, Pseudomonas sp, Proteus sp, Bacillus sp, Aspergillus sp and Candida sp.
Results: Among the total fractions obtained, few active fractions inhibited growth of organisms which would significantly serve as a potential source for new antimicrobial compounds. GCMS was performed to identify the potential compound to be Phytol exhibiting antimicrobial activity.
Conclusion: The antimicrobial activity of the bioactive compounds was tested against various microorganisms and the diameter of the zone obtained was calculated where the petroleum ether fractions exhibited good inhibition and ethanolic fractions does not have inhibitory activity.
Keywords: Saraca asoca, Ethanol, Chloroform, Petroleum ether, Ethyl acetate, Antimicrobial activity.
© 2016 The Authors. Published by Innovare Academic Sciences Pvt Ltd. This is an open access article under the CC BY license (http://creativecommons.org/licenses/by/4.0/)
INTRODUCTION
Saraca asoca which is also called Saraca indica is the ancient tree of the family Caesalpinaceae. This tree is considered as the first in medicinal values since the Buddist period and also, the lord Buddha is believed to be born under the asoca tree. It is commonly called as “Ashoka “which is a Sanskrit word meaning “without sorrow”. It is believed that the very touch of asoca tree removes the worries and anxiety of human being. It is believed from ancient period of time that asoca tree is close to women’s physical and mental health and also it is a tree of peace and happiness. It is traditionally found in India, Burma, Malaya. In India, it belongs to the Deccan plateau, Western ghats, Himalaya, Bengal. Ashoka is 10-15 m tall with long, beautiful, green foliage and attractive, a fragrant bunch of flowers with yellow and orange colors.
In India, Ashoka is traditionally used in the treatment of excessive uterine bleeding, dysmenorrhoea and depression in women. It is also used to treat inflammation, indigestion and also abnormal vaginal discharge. It is found to have antimicrobial, anticancer, antihemorrhagic, anti-oxytocic activities [6].
MATERIALS AND METHODS
Collection of samples
Saraca asoca leaves were collected from Kollam (Kerala). The leaves were shade dried and powdered well.
Preparation of extracts
The powdered leaves were soaked overnight in aqueous, ethanol and petroleum ether solvents in 1:10 ratio.5grams of the sample were soaked in 50 ml of aqueous solution, ethanol and petroleum ether solvents. The next day the soaked samples (aqueous, ethanol, petroleum ether samples) were filtered into separate beakers using filter paper. The dry weight of the samples was obtained.
Thin layer chromatography (TLC)
TLC was run for the crude sample and the mobile phase solvent was standardized using different ratios of solvents. Ethanolic extract of the sample was run with 100% chloroform. Petroleum ether extract of the sample was standardized for column chromatography and separated using TLC were 6:4 (petroleum ether: ethyl acetate) was standardized as the mobile phase.
Column chromatography (CC)
Column chromatography for ethanolic extract
The column was prepared as mentioned above with 100% chloroform as mobile phase. Filter dried ethanolic extract of the sample was mixed with the solvent and silica gel. It was dried using a water bath and the dried extract with silica was scrapped and put into a butter paper and it was loaded onto the top of the packed column. Once after the sample was loaded, the solvent was poured and the set up was observed for separation of fractions. The fractions were collection in test tubes and TLC for each fragment were performed to check the purity of the fractions and the Rf values were calculated by the formula,
![]()
The solvent was allowed to evaporate and the dry weight of the fractions was noted.
Column chromatography for petroleum ether extract
The column was set up with 6:4 ratio of petroleum ether and ethyl acetate, with silica gel. The extract was mixed with silica gel and petroleum ether and then dried with the help of water bath. The dried powder was loaded onto the column, the solvent was poured and the column was allowed to run. The separated fractions were collected, TLC was run for each fraction and the Rf values were calculated. The solvents were evaporated, the dried fractions were weighed and then stored.
Phytochemical screening of the plant sample
5 gm of the sample was dissolved in aqueous, ethanol and petroleum ether, in the ratio of 1:10. Kept overnight and the phytochemical screening was performed for all the filtered extracts. The following tests were performed [1].
1 ml of the filtrate was taken and few drops of Mayer’s reagent was added and observed for yellow precipitate.
Few drops of Benedict’s reagent was added to the filtrate and heated gently and observed for orange-red precipitate which will indicate the presence of reducing sugars.
The extract was diluted with water to 20 ml and shaken well in a graduated cylinder for 15 min. Formation of 1 cm thickness layer indicates the presence of saponins.
The extract was mixed with chloroform and filtered, few drops of acetic anhydride were added to the filtrate, boiled and cooled and conc. sulphuric acid was added. Formation of the brown ring at the junction indicates the presence of phytosterols.
Few drops of ferric chloride were added to the filtrate and the formation of bluish black color indicates the presence of phenols.
The extract was taken and 1% gelatin solution containing Sodium chloride was added to it and observed for white precipitate.
Few drops of Sodium hydroxide were added to the extract, formation of intense yellow color which becomes colorless on the addition of dilute acid indicates the presence of flavonoids.
Concentrated Nitric acid was added to the extract, formation of yellow color indicates the presence of proteins.
The extract was mixed with 0.25% w/v ninhydrin reagent and boiled for few minutes. Formation of a blue color indicates the presence of amino acids.
Extracts were dissolved in water and few drops of copper acetate solution were added. Formation of emerald green color indicates the presence of diterpenes.
Testing of antimicrobial activity of the purified fractions
Antimicrobial activity of ethanolic, petroleum ether was tested. The organisms used for testing were Escherichia coli, Staphylococcus sp, Streptococcus sp, Pseudomonas sp, Proteus sp, Bacillus sp, Aspergillus sp and Candida sp. Overnight cultures were prepared with nutrient broth.
Preparation of plates and antimicrobial testing
Muller-Hinton Agar (MHA) for antibacterial testing and SDA for antifungal testing were prepared, autoclaved and the media was poured onto the Petri plates and allowed to solidify, each organism was swabbed onto the plates under sterile conditions. The antimicrobial testing was done in well method where the samples were loaded in the well. The plates were incubated @ 37˚C for 24hr and the zone of inhibition was observed. The diameter of the zone was measured in mm [9].
Table 1: The dry weight of the filtered extracts
| S. No. | Plant name and solvent crude extracts | Initial weight in gm. | The dry weight of the crude extract in gm. |
| 1 | Ethanol | 5 | 0.48 |
| 2 | Aqueous | 5 | 1.0 |
| 3 | Petroleum Ether | 5 | 0.4 |
RESULTS AND DISCUSSION
TLC of crude extracts
100% chloroform was standardized as mobile phase and distinct bands were obtained in the silica plate. Petroleum ether and ethyl acetate in the ratio 6:4 was standardized as mobile phase and distinct bands were obtained in TLC.
Column chromatography
Ethanolic extract
Four different fractions were collected and TLC was performed for the same to check the purity of the compounds.
Petroleum ether extract
Three fractions were obtained and checked the purity by TLC
Table 2: Dry weight of the obtained fractions of ethanolic extract
| No. of fractions | Dry weight in gm |
| 1 | 0.13 |
| 2 | 0.56 |
| 3 | 0.68 |
| 4 | 0.60 |

Fig. 1: Seperation of different fractions

Fig. 2: Collected fractions by column chromatography
Table 3: Dry weight of the petroleum ether extract
| No. of fractions | Dry weight in gm |
| 1 | 0.03 |
| 2 | 0.02 |
| 3 | 0.01 |

Fig. 3: Seperation of fractions by CC
Phytochemical screening of the plant sample
Preliminary qualitative Phytochemical Screening was done to test the presence of alkaloids, Carbohydrate, Saponin, Phytosterol, Phenol, Tanins, Flavanoids, Protein, amino acids and Diterpenes for the samples. The results obtained from the phytochemical screening of ethanolic, petroleum ether and aqueous extract of the sample are tabulated below.
Phytochemical screening was carried out for the aqueous extract, ethanol and petroleum ether extract. Alkaloids were present only in the petroleum ether extract where as absent in the ethanol and aqueous extract. Tannins ans Carbohydrates were absent in all the three extracts. Saponins, phytosterols and proteins were present in all the three extarcts. Diterpenes and Phenols were present only in the aqueous and ethanl extracts. Amino acid was present only in the aqueous extract. (fig. 5, 6, 7)

Fig. 4: Collected fraction
Table 4: Number of purified fractions rom saraca asoca
| S. No. | Plant Name and Solvent crude extract | No. of fractions Obtained |
| 1. | Ethanol | 4 |
| 2. | Petroleum Ether | 3 |
Table 5: The results obtained from the phytochemical screening of ethanolic, petroleum ether and aqueous extract of the sample
S. No. |
Test |
Extract |
||
Aqueous |
Ethanol |
Petroleum ether |
||
1 |
Alkaloids (Mayer’s test) |
_ |
_ |
+ |
2 |
Carbohydrate (Benedict's test) |
_ |
_ |
_ |
3 |
Saponins (froth test) |
+ |
+ |
+ |
4 |
Phytosterols (Libermann Burchard’s test) |
+ |
+ |
+ |
5 |
Phenols (Ferric chloride test) |
+ |
+ |
_ |
6 |
Tannins (gelatin test) |
_ |
_ |
_ |
7 |
Flavanoids (lead acetate test) |
+ |
_ |
+ |
8 |
Protein (Xanthoproteictest) |
+ |
+ |
+ |
9 |
Amino acid (Ninhydrin test) |
+ |
_ |
_ |
10 |
Diterpenes (copper acetate test) |
+ |
+ |
_ |
(Note: +indicates positive and–indicates negative results)

Fig. 5: Phytochemical screening of ethanolic extract (the test tubes are arranged in the order as in the table)

Fig. 6: Phytochemical screening of petroleum ether extract (test tubes are arranged as mentioned in the table)

Fig. 7: Phytochemical screening of aqueous extract (test tubes are arranged as in the table)
Fig. 8: Antimicrobial activity of ethanolic, petroleum ether and crude extracts
Table 6: Antimicrobial activity of the ethanolic, petroleum ether fractions, and crude extracts
Microorganisms |
Zone of inhibition in (mm) |
|
||||||||||
Crude sample |
Petroleum ether fractions |
Ethanol fractions |
|
|||||||||
I Aqueous |
II Ethanol |
III P. Ether |
F1 |
F2 |
F3 |
F1 |
F2 |
F3 |
F4 |
|
||
Escherisia coli |
20 |
25 |
20 |
15 |
10 |
10 |
0 |
0 |
0 |
0 |
|
|
Enterobacter sp |
15 |
20 |
15 |
15 |
20 |
15 |
0 |
0 |
0 |
0 |
|
|
Streptococcus sp |
0 |
30 |
0 |
0 |
0 |
0 |
0 |
0 |
0 |
0 |
|
|
Pseudomonas sp |
15 |
20 |
15 |
10 |
10 |
10 |
|
0 |
0 |
0 |
0 |
|
Proteus sp |
15 |
20 |
20 |
25 |
20 |
30 |
0 |
0 |
0 |
0 |
|
|
Bacillus sp |
0 |
30 |
15 |
25 |
20 |
20 |
0 |
0 |
0 |
0 |
|
|
Aspergillus sp |
20 |
5 |
10 |
40 |
20 |
10 |
0 |
0 |
0 |
0 |
|
|
Candida sp |
50 |
10 |
10 |
0 |
0 |
0 |
0 |
0 |
0 |
0 |
|
|
From table 6, In general, the crude aqueous, ethanol and petroleum ether extracts exhibited very good antimicrobial activity when compared to the purified fractions. The petroleum ether fraction showed a significant antimicrobial activity whereas, the ethanol extracts had no activity against the pathogens.
GCMS analysis
Gas chromatography-mass spectroscopy analysis were carried out in the purified fractions of Saraca asoca The thin layer chromatography (TLC) of ethanol extract; petroleum ether extract were compared with the GC-MS profile to identify the probable bioactive compound. The peaks in the chromatogram were integrated and were compared with the database of the spectrum of known components already stored in the GC-MS library. The GCMS analysis in correlation with the TLC results the bioactive compound was identified as Sitosterol, which exhibited an good antimicrobial activity.
The fig. 9 and fig. 10 shows the GCMS result of Ethanol crude extract and Petroleum Ether crude extract.
The GC MS of ethanolic crude contains the compound, ISOQUINOLIN-7-OL, 6-METHOXY-1-[3-BENZYLOXY-4-METHYL OXYPHENYL]-and the petroleum ether crude contains PHYTOL compound.

Fig. 9: GC MS result of ethanolic crude extract

Fig. 10: GC MS result of petrolelum ether
CONCLUSION
The leaf sample of S. asoca were collected, shade dried and powdered. From the sample ethanolic, petroleum ether and aqueous extracts were prepared in the ratio of 1:10. TLC was run and the mobile phase was standardized as 100% chloroform for ethanolic crude and 6:4(petroleum ether and ethyl acetate) for petroleum ether crude. CC was run for both the extracts and the fractions obtained were collected, dried and weighed. There were 4 fractions of ethanolic crude and 3 fractions of petroleum ether crude. The antimicrobial activity of the bioactive compounds were tested against various microorganisms and the diameter of the zone obtained were calculated where the petroleum ether fractions exhibited good inhibition and ethanolic fractions does not have inhibitory activity.
ACKNOWLEDGEMENT
We thank University Grant Commission for their financial support during the study.
CONFLICT OF INTERESTS
Declare none
REFERENCES